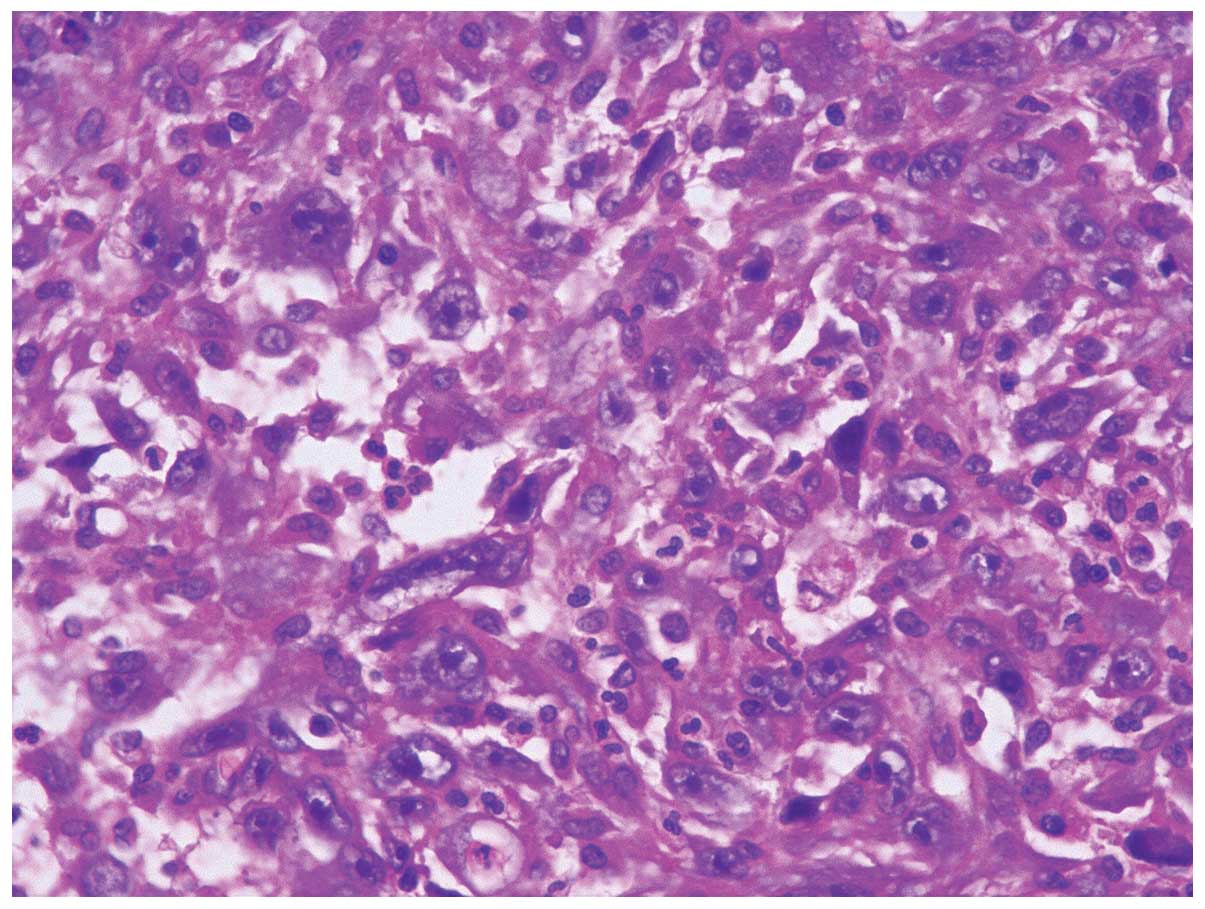

Introduction
Sarcomatoid carcinomas are a rare type of tumor,
particularly in the stomach (1).
Snover et al (2) first
described the features of sarcomatoid carcinoma. A diagnosis of
sarcomatoid carcinoma should be made when the sarcomatous component
of the tumor mainly consists of spinal cells, but the cells are
morphologically or immunologically identifiable as epithelial cells
(3). Occasionally the tumors exhibit
specific, notable differentiation, for example osteoclastic-like
giant cells (4). Due to the poor
efficacy of chemotherapy and radiotherapy, surgery remains the most
effective treatment (5,6). The present report presents details of a
large-size sarcomatoid carcinoma in the stomach, which was
completely resected by surgery. In addition, complete clinical data
is included.
Case report
A 49-year-old Chinese male with melena, anemia and
fatigue visited the Emergency Room at Ren Ji Hospital Affiliated to
Shanghai Jiao Tong University School of Medicine (Shanghai, China),
on July 22, 2013. The proband's hemoglobin was 39 g/l upon entering
the ward. Abdominal ultrasonography revealed a mass with mixed
echogenicity in the right upper quadrant of the abdomen. A computed
tomography (CT) scan revealed a 14 cm-diameter mass in the gastric
antrum and gastric body, which infiltrated the serosa of the
stomach. The gallbladder and hepatic flexure of the colon were also
involved. CT contrast enhancement was evident in the two lesions
(Figs. 1 and 2). A positron emission tomography (PET)-CT
scan revealed a large irregular mass with abnormally high
fluorodeoxyglucose (FDG) metabolism in the region of the distal
stomach, gallbladder fossa and hepatic tissue in the vicinity
(Fig. 3). A lymph node with high FDG
metabolism was observed in the region of the pancreatic head
(Fig. 4). Endoscopic investigation of
the upper gastrointestinal tract identified an irregularly shaped
lesion on the gastric antrum and body (Fig. 5). The histopathological section of the
endoscopic biopsy revealed that the majority of the tumor cells
were spindle shaped in morphology. Following a primary diagnosis of
gastric malignancy, the patient received surgery on August 3, 2013.
A 14×13×8 cm, solid mass with an irregular surface was identified
during surgery. In addition, the No. 13 lymph nodes were markedly
enlarged and fused, measuring 20×35 mm. The distal stomach,
gallbladder and right hemicolon were resected in order to
completely remove the tumor. In addition, an extended D2
lymphadenectomy was also performed. Reconstruction was conducted
with the gastrojejunum Roux-en-Y anastomosis (7). Histopathological diagnosis was as
follows: Sarcomatoid carcinoma of the gastric antrum and body
(14×13×8 cm in size, with serosa invasion), the gallbladder and
adjacent colon wall were also involved and No. 13 lymph node
metastasis was observed.
Following surgery, the patient recovered
successfully and was discharged from hospital on August 19, 2013.
However, the tumor recurred and the patient succumbed to the
disease in February 2015.
Pathological findings
Macropathological analysis of the resected specimen
revealed a mass with an irregular surface, measuring 14×13×8 cm
(Fig. 6). The cross-sectional surface
of the tumor was gray-white in appearance. Paraffin-embedded,
4–6-µm-thick specimens were mounted on microscopic slides.
Following deparaffinization, tissue samples were postfixed in
buffered osmium tetroxide, dehydrated in ethanol and embedded.
Ultrathin sections were prepared and examined using a transmission
electron microscope (Axio Imager A1; Carl Zeiss, Ltd., Cambridge,
UK).
Micropathologically, the tumor cells of the stomach
demonstrated infiltrative growth. The cytological characteristics
of the tumor cells revealed overtly malignant features. Microscopic
observation identified mainly spindle-shaped cell structures with
significantly atypical, pleomorphic and giant nuclei. In addition,
a minority area of adenocarcinoma, with papillary and tubular
growth of cancer cells, was also detected. The sarcomatous and
carcinomatous elements were frequently closely admixed with each
other throughout the tumor. There were >50 mitoses per 10
high-power fields (Fig. 7).
Immunohistochemical (IHC) examination of the
sections was performed using a standard avidin-biotin-peroxidase
complex method (8). The antibodies
used and the results obtained are summarized in Table I. The tumor cells were positive for
Vimentin (Fig. 8), cytokeratin (CK),
CK7 (Fig. 9) and CD68 (Fig. 10). Expression of the proliferation
marker Ki-67 reached 80% (Fig. 11).
The cells were negative for Desmin, CD20, CD31, CD34, CD117,
discovered on GIST-1 (DOG-1), S-100, ALDOG-1, P63, Melan-A and
human melanoma black 45 (Table
I).
 | Table I.Primary antibodies and their marked
cells, dilution, source, system and results in tumor cells. |
Table I.
Primary antibodies and their marked
cells, dilution, source, system and results in tumor cells.
| Antibody | Marker | Clonality | Source | Dilution | Result |
|---|
| P63 | Tumor cell | Monoclonal | Dako | 1:50 | – |
| S100 | Dendritic cell | Monoclonal | Dako | 1:200 | – |
| SMA | Smooth muscle
actin | Monoclonal | Dako | 1:100 | – |
| Desmin | Muscle cell | Monoclonal | Dako | 1:50 | – |
| CD68 | Pan-macrophage | Monoclonal | Dako | 1:50 | + |
| Vimentin | Stroma cell | Monoclonal | Dako | 1:100 | + |
| CD117 | Stroma cell | Monoclonal | Dako | 1:50 | – |
| DOG-1 | Stroma cell | Monoclonal | Dako | 1:50 | – |
| Ki-67 | Antigen proliferation
marker | Polyclonal | Dako | 1:50 | 80% |
| CD34 | Vascular endothelial
cell | Monoclonal | Dako | 1:50 | – |
| CD31 | Vascular endothelial
cell | Monoclonal | Dako | 1:50 | – |
| Melan-A | Melanoma | Monoclonal | Dako | 1:100 | – |
| HMB45 | Melanoma | Monoclonal | Dako | 1:100 | – |
| CK | Epithelial cell | Monoclonal | Dako | 1:50 | + |
| CK7 | Epithelial cell | Monoclonal | Dako | 1:50 | + |
| CD20 | Epithelial cell | Monoclonal | Dako | 1:20 | – |
Diagnosis of sarcomatoid carcinoma of the stomach
was confirmed by these histomorphological and IHC findings.
Discussion
Adenocarcinoma, adenosquamous carcinoma and squamous
carcinoma are more common types of tumor in stomach (9). Sarcomatoid carcinoma is a rare type of
primary gastric tumor, and it is difficult to make a definitive
pre-operative diagnosis in such cases. Reviewing the clinical data
of the present case, further characters of gastric sarcomatoid
carcinoma have been identified. The histopathological section of
endoscopic biopsy revealed that the majority of the tumor cells
were spindle shaped in morphology. In addition, minor elements with
adenocarcinoma were also observed. In terms of radiography, PET-CT
scans provided greater clarity in concluding correct diagnosis.
However, final diagnosis remains dependent on the
results of the IHC exam (6,10). The present tumor was finally diagnosed
as sarcomatoid carcinoma, since IHC analysis was positive for
epithelial markers in the mesenchymal elements of the tumor.
Reviewing the current case and 5 previously reported cases from the
literature (11–13), the characteristics of all reported
cases are summarized in Table II.
The age of the patients ranged from 47–78 years old (mean, 62.7
years). All previously reported tumors were located close to the
gastroesophageal junction, whereas the present tumor was located in
the distal stomach. A total of 5 out of the 6 patients from the
literature, including the case reported in the present study,
underwent surgical resection. The size of the tumor in the present
case was the largest. In the sixth case, the patient with a 20-cm
diameter tumor died prior to surgical intervention due to
respiratory failure. A total of 4 out of the 5 resectable cases,
except for the present case, developed recurrence within several
months, indicating that the prognosis of this disease is relatively
poor.
 | Table II.Summary of reported cases of gastric
sarcomatoid carcinoma. |
Table II.
Summary of reported cases of gastric
sarcomatoid carcinoma.
| Author | Gender | Age, years | Tumor location | Size, cm | Therapy | Outcome | Refs |
|---|
| Nakayama et
al | M | 69 | Remnant stomach | 20 | None | Succumbed to heart
failure | (11) |
| Robey-Cafferty et
al | M | 78 | Greater
curvature | 5 | Surgery | Succumbed 45 months
later | (12) |
| Robey-Cafferty et
al | F | 57 | Lesser curvature | 5 | Surgery | Succumbed 5 months
later | (12) |
| Robey-Cafferty et
al | F | 47 | Gastroesophageal
junction | 5 | Surgery | Alive 8 months
post-surgery | (12) |
| Sato et
al | M | 74 | Remnant stomach | 4 | Endoscopy | Alive 7 months
post-endoscopy | (13) |
| Present case | M | 49 | Distal stomach | 14 | Surgery | Alive 2 months
post-surgery |
|
The understanding of sarcomatoid carcinoma has been
hindered by variations in nomenclature and classification. Multiple
nomenclatures have been used in the previous literature, including
carcinosarcoma, pseudosarcoma, pseudocarcinoma and spindle cell
carcinoma. The multiple names demonstrate the varied understandings
of this disease, which have resulted in complex definitions
regarding this type of tumor.
It is highlighted in the current literature that
sarcomatoid carcinomas display malignant epithelial and stromal
components, and sarcoma components which occupy >50% of the
elements involved. Sarcomatoid cancer is able to develop in
numerous locations, including the nasopharynx, lung, digestive
tract, urinary and genital system (3,5,10,14).
Sarcomatoid cancer, in the skin or mucous membrane, presents
similarly to polypus under a microscope, and IHC may be used to
detect the presence of various types of sarcomatoid properties, for
example clusters of well-differentiated cells, and demonstration of
intraepithelial neoplasia without the element of cancer. The
sarcomatoid cancer has elements of both cancer and sarcoma. In the
immune phenotype analysis, the properties of the cancer part remain
constant in CK and epithelial membrane antigen (EMA). By contrast,
the phenotypes of sarcoma part vary. The positive rates of CK and
EMA are 26% and 17.9%, respectively (10).
The pathogenic mechanisms underlying sarcomatoid
carcinoma remain to be elucidated. P53 mutations have been observed
in this kind of tumor. Certain scientists have hypothesized that
sarcomatoid carcinoma may be differentiated from stem cells
(15), as the carcinomatous and
sarcomatoid elements are monoclonal. Two of the previous cases of
sarcomatoid carcinoma were discovered on remnant stomach. Studies
have reported that a large proportion of sarcomatoid carcinomas
developed in various organs following treatment for other diseases
(16). For example, these tumors were
found in the urinary system following transurethal resection or
chemotheraphy, and in the liver following arterial embolization or
radiofrequency ablation.
The prognosis of sarcomatoid carcinoma is poor,
therefore the patient in the present case may present with an
unfavorable prognosis. Furthermore, the large size of the tumor and
the involvement of No. 13 lymph node metastases and adjacent organs
decrease the probability of a favorable prognosis. The thoroughness
of surgical resection is the most significant factor underlying
patient survival. Although sarcomatoid carcinoma is insensitive to
chemotherapeutic drugs (5), certain
patients were demonstrated to benefit from chemotherapy with a
carbopaltin and gemcitabine regime (17). However, whether or not to treat
gastric sarcomatoid carcinoma with chemotherapy remains a
controversial issue.
Reports on giant sarcomatoid carcinoma are
infrequent. The present case of sarcomatoid carcinoma of the
stomach therefore presented a rare opportunity for study. Resection
of such a large size tumor presented difficulties, and it was a
challenge to completely resect. The curative effect of adjuvant
therapies for gastric sarcomatoid carcinoma remains unclear, and
therefore follow-up of this patient is important for enhancing
understanding of the disease.
Acknowledgements
The present study was supported by the Project of
Science and Technology Commission of Shanghai Municipality (no.
13ZR1425200) and the Project of Shanghai Municipal Health Bureau
(no. 20114241).
References
|
1
|
Carboni F, Levi Sandri GB, Valle M,
Covello R and Garofalo A: Gastric sarcomatoid carcinoma. J
Gastrointest Surg. 17:2025–2027. 2013. View Article : Google Scholar : PubMed/NCBI
|
|
2
|
Snover DC, Levine GD and Rosai J: Thymic
carcinoma. Five distinctive histological variants. Am J Surg
Pathol. 6:451–470. 1982. View Article : Google Scholar : PubMed/NCBI
|
|
3
|
Cheng L, Huang WB and Rao Q: Molecular
pathology, histopathologic features and differential diagnosis of
sarcomatoid carcinoma of urinary bladder. Zhonghua Bing Li Xue Za
Zhi. 42:416–419. 2013.(In Chinese). PubMed/NCBI
|
|
4
|
Yozu M, Glengarry J and Ahmed SS:
Cutaneous squamous cell carcinoma associated with proliferation of
osteoclast-like giant cells. J Pak Med Assoc. 61:922–925.
2011.PubMed/NCBI
|
|
5
|
Huang SY, Shen SJ and Li XY: Pulmonary
sarcomatoid carcinoma: A clinicopathologic study and prognostic
analysis of 51 cases. World J Surg Oncol. 11:2522013. View Article : Google Scholar : PubMed/NCBI
|
|
6
|
Chien T, Chou J, Chang T and Lin C:
Successful treatment of biphasic metaplastic sarcomatoid carcinoma
of the breast by evaluation of immunohistochemical markers. Hematol
Oncol Stem Cell Ther. 3:89–93. 2010. View Article : Google Scholar : PubMed/NCBI
|
|
7
|
Langhans P, Schönleben K and Bünte H: The
routine use of Roux-en-Y anastomosis in gastric surgery. Scand J
Gastroenterol Suppl. 67:247–249. 1981.PubMed/NCBI
|
|
8
|
Charpin C, Martin PM, Lissitzky JC, Lavaut
MN, Kopp F, Pourreau-Schneider N, Jacquemier J and Toga M:
Immunocytochemical antigens detection in human breast carcinomas: A
light and electron microscopy study using avidin biotin peroxidase
and preembedding method. Cancer Detect Prev. 8:77–85.
1985.PubMed/NCBI
|
|
9
|
Corso G, Seruca R and Roviello F: Gastric
cancer carcinogenesis and tumor progression. Ann Ital Chir.
83:172–176. 2012.PubMed/NCBI
|
|
10
|
Viswanathan S, Rahman K, Pallavi S, Sachin
J, Patil A, Chaturvedi P, D'Cruz A, Agarwal J and Kane SV:
Sarcomatoid (spindle cell) carcinoma of the head and neck mucosal
region: A clinicopathologic review of 103 cases from a tertiary
referral cancer centre. Head Neck Pathol. 4:265–275. 2010.
View Article : Google Scholar : PubMed/NCBI
|
|
11
|
Nakayama Y, Murayaama H, Iwasaki H,
Iwanaga S, Kikuchi M, Ikeda S, Okada M, Iizuka Y and Iwashita A:
Gastric carcinosarcoma (sarcomatoid carcinoma) with
rhacdomyoblastic and osteoblastic differentation. Pathol Int.
47:557–653. 1997. View Article : Google Scholar : PubMed/NCBI
|
|
12
|
Robey-Cafferty SS, Grignon DJ, RoJ Y,
Cleary KR, Ayala AG, Ordonez NG and Mackay B: Sarcomatoid carcinoma
of the stomach. A report of three cases with immunohistochemical
and ultrastructural observations. Cancer. 65:1601–1606. 1990.
View Article : Google Scholar : PubMed/NCBI
|
|
13
|
Sato A, Oki E, Kohso H, Endo Y, Uchida H,
Hiroshige S, Ishida M, Saito G, Matsumoto T, Takeuchi H, Kusumoto
T, Yoshikawa Y and Muto Y: Sarcomatoid carcinoma of the remnant
stomach: report of a case. Surg Today. 43:308–312. 2013. View Article : Google Scholar : PubMed/NCBI
|
|
14
|
Ren CL, Jin P, Han CX, Xiao Q, Wang DR,
Shi L, Wang DX and Chen H: Unusual early-stage pancreatic
sarcomatoid carcinoma. World J Gastroenterol. 19:7820–7824. 2013.
View Article : Google Scholar : PubMed/NCBI
|
|
15
|
Znati K, Tadlaoui N, Bernoussi Z, Mikou A,
Mahassini N, Jahid A, Mansouri F and Hachimi A: Biphasic
sarcomatoid carcinoma of the thyroid: An exceptional localization
of a rare tumor. Ann Endocrinol (Paris). 67:64–68. 2006.(In
French). View Article : Google Scholar : PubMed/NCBI
|
|
16
|
Badhiwala N, Chan R, Zhou HJ, Shen S and
Coburn M: Sarcomatoid carcinoma of male urethra with bone and lung
metastases presenting as urethral stricture. Case Rep Urol.
2013:9318932013.PubMed/NCBI
|
|
17
|
Sugano T, Mori M, Namba Y, Uenami T,
Kagami S and Yokota S: A case of sarcomatoid carcinoma of the lung
successfully treated with carboplatin, paclitaxel and bevacizumab.
Nihon Kokyuki Gakkai Zasshi. 49:304–308. 2011.(In Japanese).
PubMed/NCBI
|